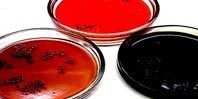

Антисептическая бумага, в отличие от обычной, перестает быть удобной средой для размножения бактерий. К тому же, антисептики делают банкноты более долговечными. Плюс, в последнее время на банкноты отдельного номинала начали наносить специальное лаковое покрытие, которое дополнительно защищает бумажные деньги от загрязнения.
По словам представителей «Госзнака», российские стандарты по выводу ветхих банкнот из обращения находятся примерно на одном уровне с еврозоной. То есть загрязненные банкноты вовремя уничтожаются Банком России. Это предотвращает распространение опасных патогенов. Но в любом случае эксперты рекомендуют при использовании и хранении бумажных денег избегать сырости и грязи, а после пользования банкнотами — мыть руки.